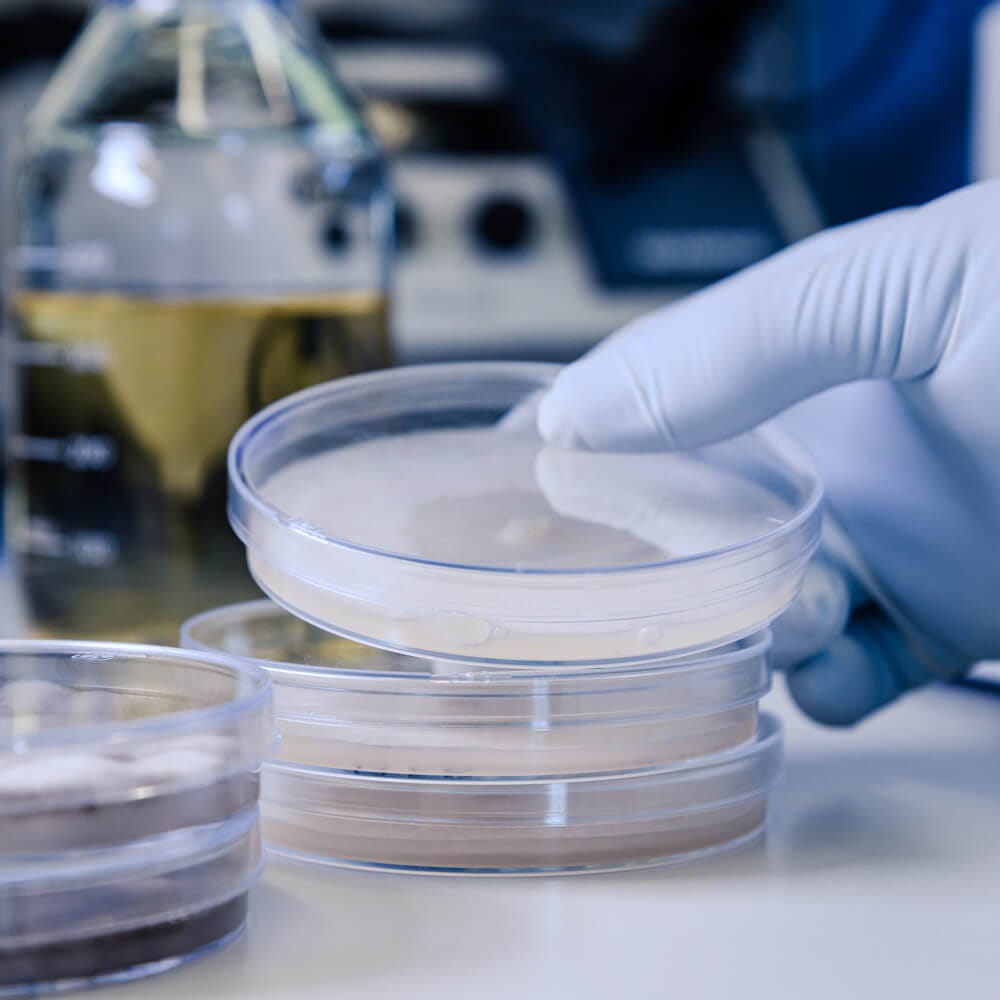
solabia-cropped-hand-scientist-holding-petri-dishes-table-1
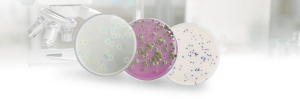
card-metodos-alternativos-biokar-laborclin-blog

Solabia Diagnósticos Brasil
Uma nova estrutura. O mesmo compromisso e qualidade de sempre.
swab-srk
A linha de amostragem ambiental serve para avaliar
microrganismos em superfícies e equipamentos.
Segmentos que atendemos
Laboratórios de Análises Clinicas
Indústria Farmacêutica
Indústria de Cosméticos
Indústria de Alimentos e Bebidas
Medicina Veterinária
Pesquisas Biológicas
Solabia Diagnósticos Brasil
A Solabia Diagnósticos Brasil integra a atuação do Grupo Solabia no país, unindo expertise local e inovação científica global em microbiologia e diagnóstico.
Oferecemos soluções confiáveis para laboratórios e indústrias, com foco em qualidade, segurança e excelência técnica.
Notícias
Solabia
Você conhece os diferenciais dos meios cromogênicos Biokar? Reunimos aqui respostas para algumas das dúvidas mais comuns sobre nossas soluções...
publicado em
Solabia
Com mais de meio século de inovação e excelência, o Grupo Solabia consolida sua posição de liderança nos setores farmacêutico,...
publicado em
Microbiologia
As tendências, desafios e oportunidades do mercado de insumos de microbiologia para o ano de 2025
publicado em
Microbiologia
As tendências, desafios e oportunidades do mercado de insumos de microbiologia para o ano de 2025
publicado em